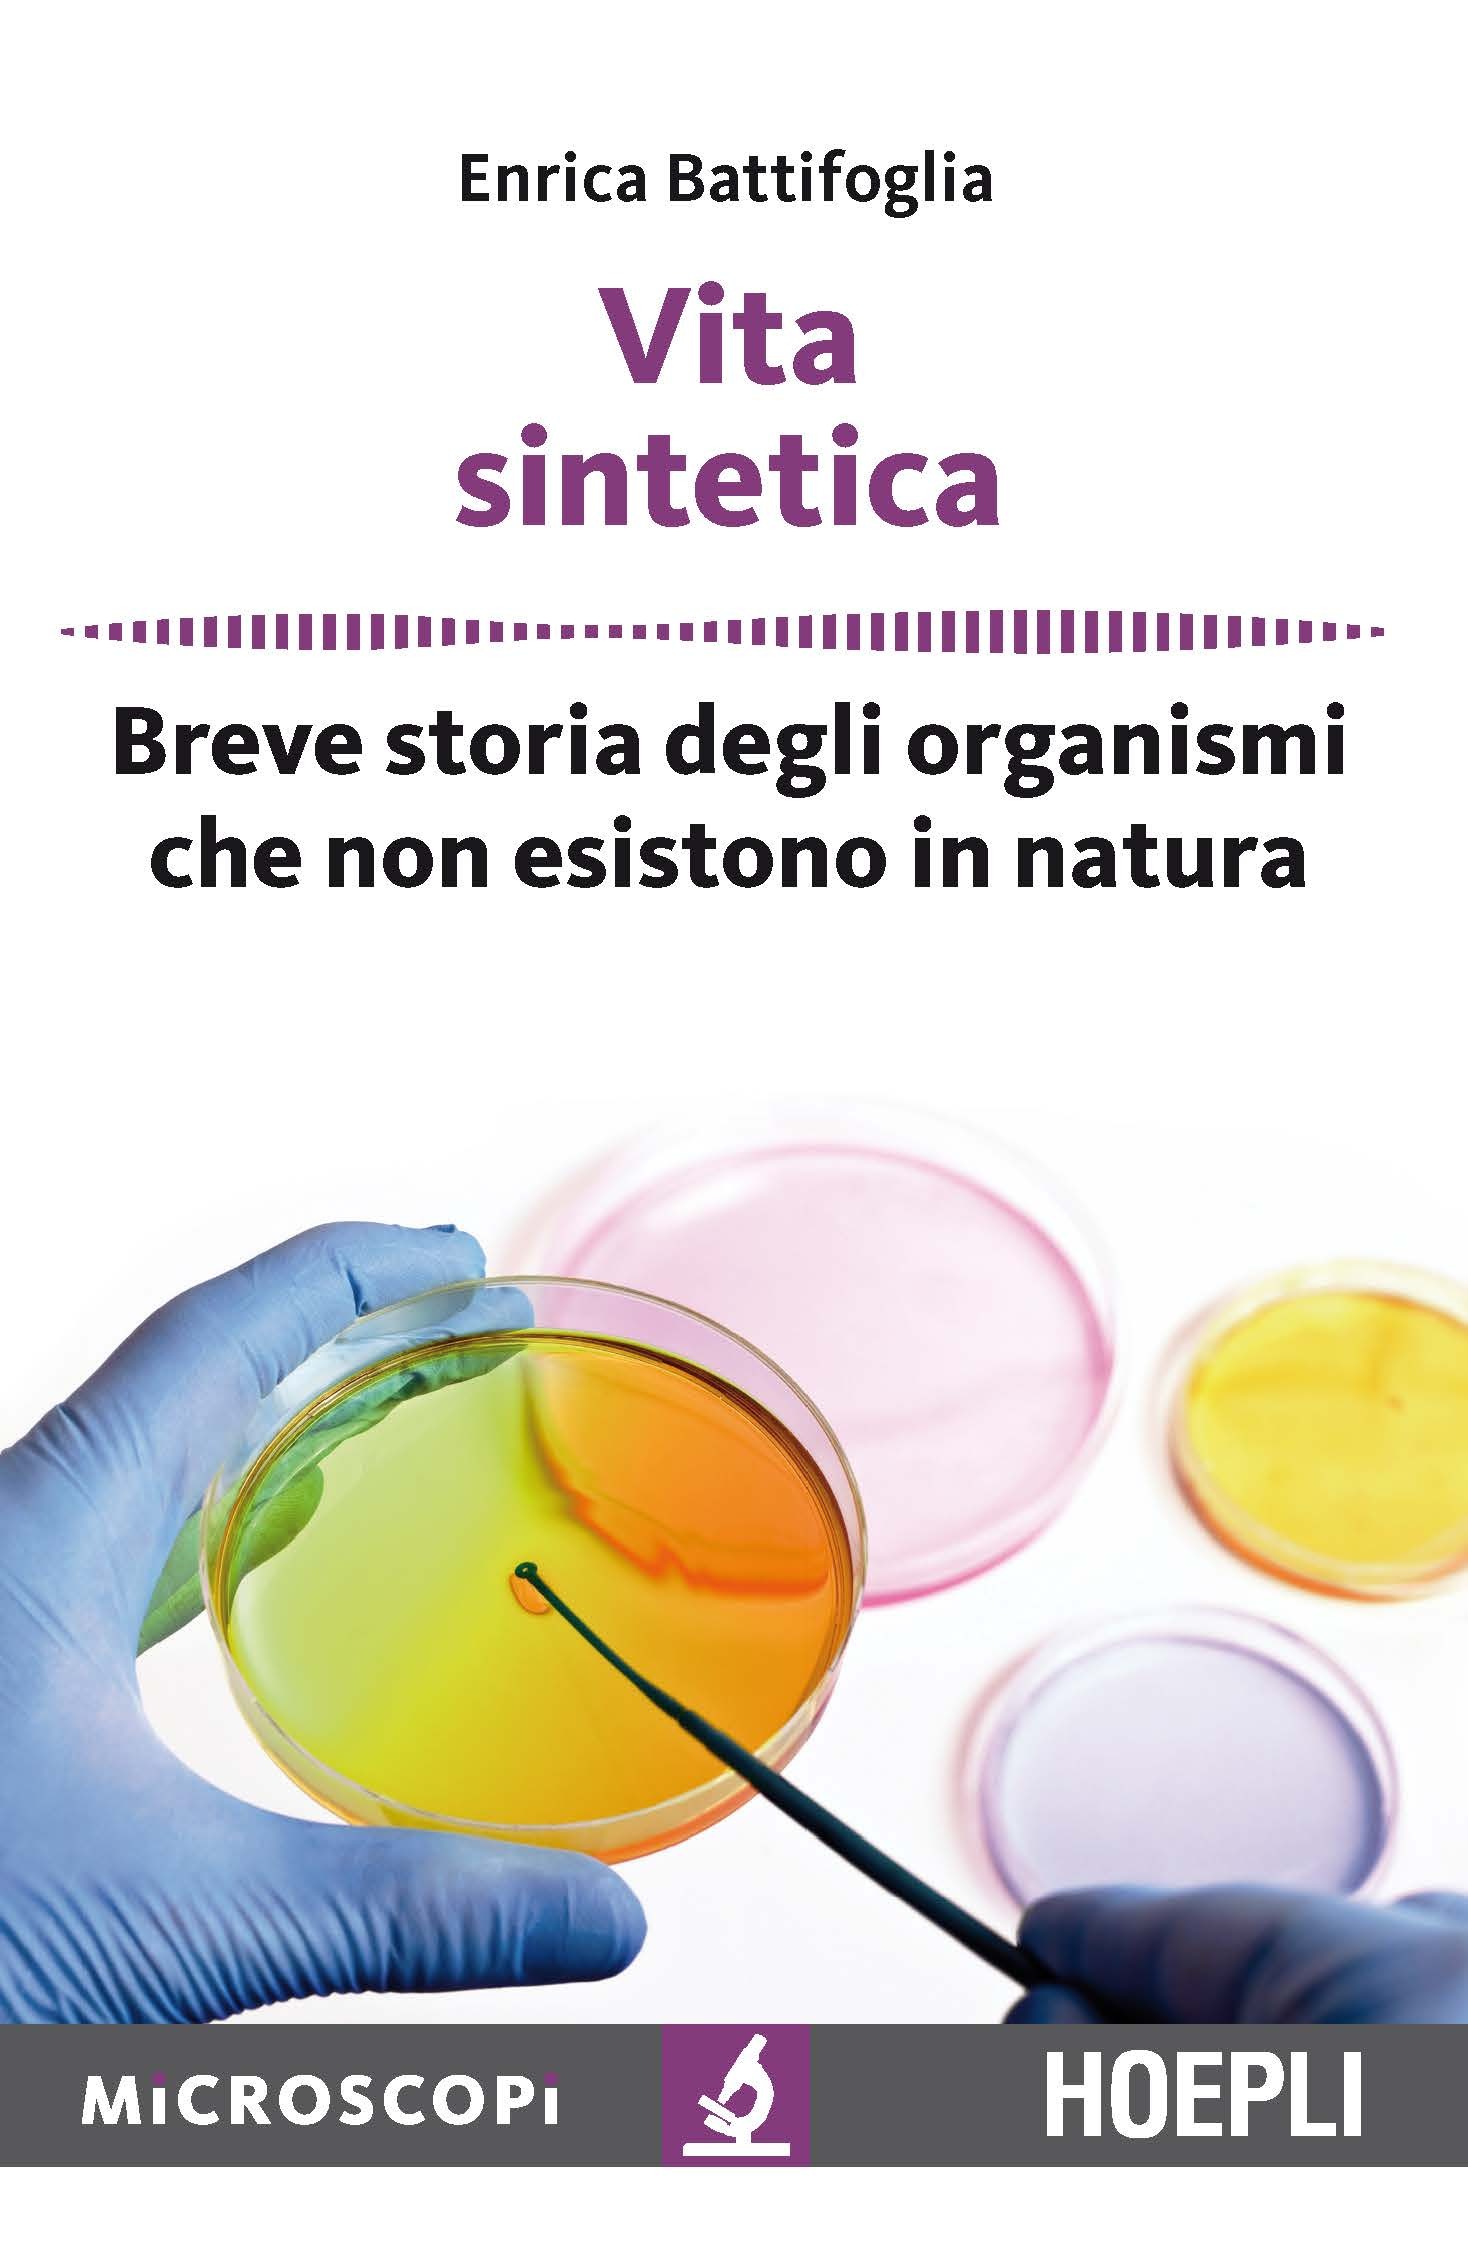
ibs

Formato tascabile, amabile per i viaggi, continente alcune delle novità nel campo della manipolazione genetica. Regalato a mia moglie che ne è rimasta entusiasta. Acquisterò altri libri della collana microscopi Hoepli
Vita sintetica. Breve storia degli organismi che non esistono in natura
Prezzo minimo ultimi 30 giorni: 4,52 €
Tra incubatori, centrifughe e pipette, e soprattutto con l'aiuto di potentissimi computer, nei laboratori di biologia sono già nate le prime forme di vita sintetica, vale a dire esseri viventi che non esistono in natura. Sono organismi apparentemente molto semplici, come i batteri, ma il loro Dna non è mai esistito sulla faccia della Terra perché è stato progettato dall'uomo. Sono una sorta di app della vita, di certo incredibilmente più complessa delle app che usiamo tutti i giorni. Nemmeno la fantascienza aveva mai concepito qualcosa di simile a questa ultima frontiera delle scienze della vita. I batteri sintetici non sono mai usciti dagli straordinari laboratori in cui sono nati e probabilmente non lo faranno ancora per molto tempo. Ma quando saranno pronti per essere utilizzati in tutta sicurezza promettono di fare molto per il nostro pianeta. Potranno aiutare a ripulire acque e terreni inquinati, diventare fabbriche di farmaci 'su misura' e, in un futuro più lontano, rendere ospitali altri pianeti perché l'uomo possa esplorarli.
-
Autore:
-
Editore:
-
Collana:
-
Anno edizione:2017
Recensioni pubblicate senza verifica sull'acquisto del prodotto.
-
Stefano 18 ottobre 2022piacevole e divulgativo
Le schede prodotto sono aggiornate in conformità al Regolamento UE 988/2023. Laddove ci fossero taluni dati non disponibili per ragioni indipendenti da Feltrinelli, vi informiamo che stiamo compiendo ogni ragionevole sforzo per inserirli. Vi invitiamo a controllare periodicamente il sito www.lafeltrinelli.it per eventuali novità e aggiornamenti.
Per le vendite di prodotti da terze parti, ciascun venditore si assume la piena e diretta responsabilità per la commercializzazione del prodotto e per la sua conformità al Regolamento UE 988/2023, nonché alle normative nazionali ed europee vigenti.
Per informazioni sulla sicurezza dei prodotti, contattare productsafety@feltrinelli.it